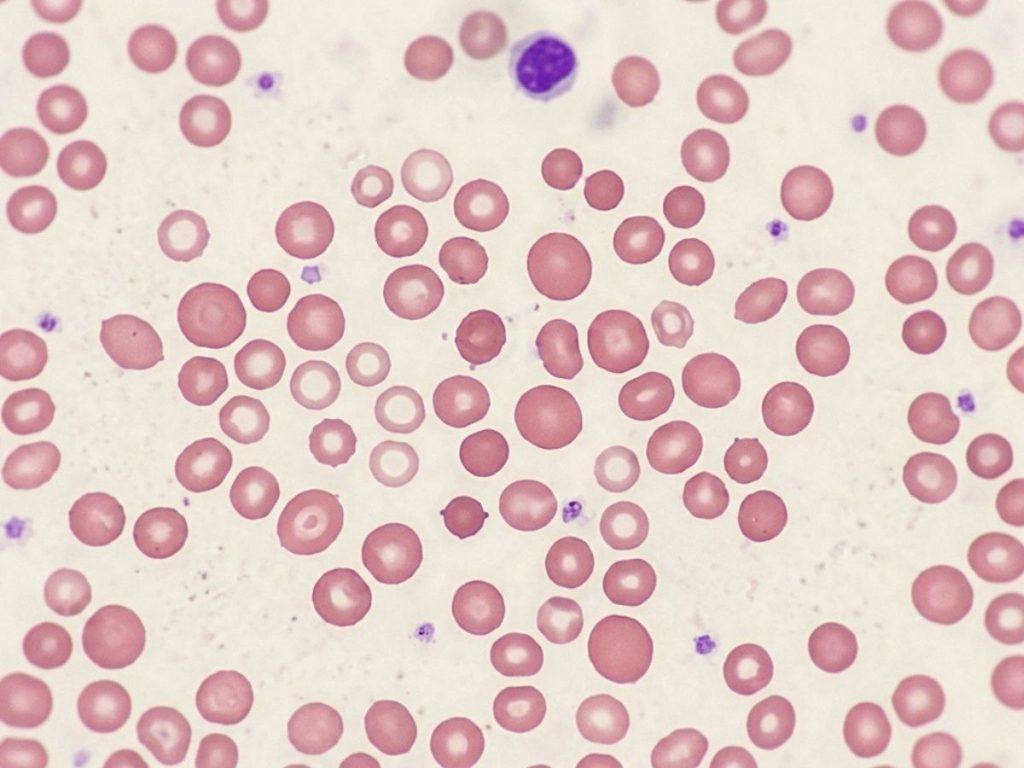

Du hast dein Blutbild vor dir und stolperst über MCV, MCH und MCHC? Dann bist du nicht allein. Genau diese drei Werte wirken auf dem Laborzettel oft wie kryptische Abkürzungen, sind aber in Wahrheit ein erstaunlich hilfreicher Blick auf deine roten Blutkörperchen. Sie zeigen nicht nur, wie viele Erythrozyten unterwegs sind, sondern auch, wie groß sie sind und wie gut sie mit Hämoglobin gefüllt sind. Genau deshalb geben sie oft eine erste Richtung vor, wenn es um Eisenmangel, Vitamin-B12-Mangel, Folsäuremangel oder verschiedene Formen von Blutarmut geht.
Von Dr. Maria Folk, Ärztin
Stand: 09.04.2026 · Medizinisch eingeordnet von Dr. Maria Folk
Was diese Blutwerte bei Eisenmangel, Vitamin B12 und Blutarmut verraten
MCV, MCH und MCHC gehören zu den Werten, bei denen viele Menschen auf ihrem Laborzettel aussteigen. Die Abkürzungen verwirren eher und am Ende bleibt nur das Gefühl, dass man es nicht wirklich versteht, was genau das alles bedeutet.
Dabei sind diese drei Werte unglaublich hilfreich. Sie gehören zu den sogenannten Erythrozyten-Indizes und geben einen detaillierteren Blick auf deine roten Blutkörperchen. Also nicht nur darauf, wie viele davon im Blut unterwegs sind, sondern auch, wie groß sie sind und wie gut sie mit Hämoglobin (roter Blutfarbstoff) gefüllt sind. Genau deshalb können sie eine erste Richtung vorgeben, wenn es um Eisenmangel, Vitamin-B12-Mangel, Folsäuremangel oder verschiedene Formen von Blutarmut geht.
In diesem Artikel schauen wir uns an, was MCV, MCH und MCHC eigentlich messen, was Begriffe wie mikrozytär, makrozytär, hypochrom oder normochrom bedeuten und warum diese Werte oft viel mehr Mehrwert liefern, als ihnen zugetraut wird.
Auf einen Blick
- MCV zeigt, wie groß deine roten Blutkörperchen im Durchschnitt sind
- MCH zeigt, wie viel Hämoglobin durchschnittlich in einem roten Blutkörperchen steckt
- MCHC zeigt, wie dicht das Hämoglobin im roten Blutkörperchen gepackt ist
Was MCV, MCH und MCHC überhaupt sind
MCV, MCH und MCHC gehören zu den Erythrozyten-Indizes. Das klingt erstmal sehr medizinisch, beschreibt aber im Grunde nur einen genaueren Blick auf deine roten Blutkörperchen.
Das MCV zeigt dir das mittlere Volumen eines roten Blutkörperchens. Vereinfacht gesagt geht es also um die Frage: Sind deine roten Blutkörperchen eher klein, normal groß oder eher vergrößert? (normo-, makro- oder mikrozytär)
Das MCH beschreibt die durchschnittliche Menge an Hämoglobin pro rotem Blutkörperchen. Das ist also die Frage: Wie viel roter Blutfarbstoff steckt durchschnittlich in einer einzelnen Zelle? (normo-, hyper- oder hypochrom)
Das MCHC zeigt, wie konzentriert dieses Hämoglobin im roten Blutkörperchen vorliegt. Es geht also nicht nur um die Menge, sondern auch darum, wie „dicht“ das Hämoglobin in der Zelle gepackt ist.
Wenn man es bildlich sagen möchte, dann ist das MCV die Größe des Transportwagens, MCH die Menge an Ladung darin und MCHC die Frage, wie dicht diese Ladung im Wagen gepackt ist.
Warum diese drei Werte so spannend sind
Viele Menschen schauen bei Erschöpfung oder Blutarmut v.a. auf das Hämoglobin. Das ist verständlich, weil dieser Wert am bekanntesten ist. Das Problem ist nur, dass ein niedriges Hämoglobin dir erstmal nur sagt, dass etwas mit der Blutbildung oder dem Sauerstofftransport nicht optimal läuft. Es sagt dir aber noch nicht besonders gut, warum. Genau hier helfen MCV, MCH und MCHC weiter und liefern oft eine Richtung. Nicht die komplette Diagnose, aber den ersten sinnvollen Hinweis. Wenn die roten Blutkörperchen eher klein und blass wirken, denkt man anders weiter als, wenn sie eher groß sind. Und genau das macht diese drei Werte so wertvoll.
MCV einfach erklärt: mikrozytär, normozytär oder makrozytär
Wenn das MCV erniedrigt ist, spricht man von einem mikrozytären Bild. Das bedeutet einfach nur, dass die roten Blutkörperchen im Durchschnitt kleiner sind als üblich. Ein solches Muster passt klassisch zu Eisenmangel.
Wenn das MCV im Normbereich liegt, spricht man von normozytär. Das klingt erstmal unauffällig, heißt aber nicht immer, dass kein Problem vorliegt. Auch bei einem normozytären Blutbild können Mangelzustände, Blutverluste oder Entzündungen im Hintergrund mitspielen (selten).
Wenn das MCV erhöht ist, spricht man von einem makrozytären Bild. Dann sind die roten Blutkörperchen im Durchschnitt größer als üblich. Das passt klassisch zu einem Vitamin-B12-Mangel oder Folsäuremangel, kann aber auch andere Ursachen haben.
Ganz grob kannst du dir also merken:
- MCV niedrig = eher mikrozytär
- MCV normal = eher normozytär
- MCV hoch = eher makrozytär

MCH und MCHC einfach erklärt: hypochrom, normochrom oder hyperchrom
Das MCH zeigt, wie viel Hämoglobin durchschnittlich in deinen roten Blutkörperchen steckt. Das MCHC zeigt, wie konzentriert dieses Hämoglobin in der Zelle vorliegt.
Wenn MCH oder MCHC erniedrigt sind, passt das häufig zu einem hypochromen Muster. Das bedeutet vereinfacht gesagt, dass die roten Blutkörperchen relativ wenig roten Blutfarbstoff enthalten oder weniger dicht damit gefüllt sind und so eher blass wirken. Genau das sieht man oft bei Eisenmangel.
Wenn MCH und MCHC im Normbereich liegen, spricht man eher von normochrom. Die Zellen wirken dann von ihrer Hämoglobin-Füllung her zunächst unauffällig.
Ein hyperchromes Bild ist deutlich seltener. Dieser Begriff taucht in manchen Schemata mit auf, spielt im Praxisalltag aber eine kleinere Rolle als hypochrom oder normochrom.
Ganz grob kannst du dir merken:
- MCH / MCHC niedrig = eher hypochrom
- MCH / MCHC normal = eher normochrom
- MCHC hoch = selten, eher besondere Konstellationen

Typische Konstellationen einfach erklärt
Jetzt wird es praktisch. Denn erst die Kombination der Werte macht richtig Sinn.
1) Mikrozytär und hypochrom
Wenn MCV niedrig ist und MCH oder MCHC ebenfalls niedrig sind, spricht man oft von einem mikrozytär-hypochromen Muster. Das passt klassisch zu Eisenmangel. Die roten Blutkörperchen sind dann tendenziell kleiner und gleichzeitig weniger gut mit Hämoglobin gefüllt. Wenn du diesen Zusammenhang besser verstehen willst, lies hier weiter: Ferritin, Eisen & Eisenmangel verstehen.
2) Normozytär und normochrom
Wenn MCV normal und MCH/MCHC ebenfalls normal sind, spricht man von einem normozytär-normochromen Bild. Das klingt erstmal beruhigend, heißt aber nicht automatisch Entwarnung. Wenn gleichzeitig das Hämoglobin abfällt, kann das zum Beispiel zu Blutverlust, Entzündungen oder anderen Formen von Blutarmut passen. Ein normozytäres, normochromes Blutbild ist also nicht automatisch „harmlos“, sondern muss im Zusammenhang gelesen werden.
3) Makrozytär und eher normochrom
Wenn MCV erhöht ist, also makrozytär, und MCHC eher normal bleibt, denkt man klassisch an Vitamin-B12-Mangel oder Folsäuremangel. Die roten Blutkörperchen sind dann eher größer, ohne dass sie automatisch ungewöhnlich „blass“ wirken müssen.
Warum diese Werte trotzdem nie allein reichen
So hilfreich MCV, MCH und MCHC auch sind, sie erzählen nie die ganze Geschichte. Sie sind Wegweiser, aber keine fertige Diagnose. Wenn die roten Blutkörperchen klein sind, ist Eisenmangel häufig, aber eben nicht die einzige Möglichkeit. Wenn sie groß sind, denkt man an Vitamin B12 oder Folat, aber auch das ist nicht die einzige Erklärung. Und wenn alles normozytär und normochrom aussieht, heißt das noch lange nicht automatisch, dass kein Mangel oder kein Problem vorliegt.
Deshalb sollte man diese Werte immer zusammen anschauen mit:
- Hämoglobin (Hb)
- Erythrozyten (Ery)
- Ferritin bzw. der Eisenstatus
- Vitamin B12
- Folsäure (Vitamin B9)
- deinen individuellen Symptomen
Was du bei auffälligen Erythrozyten-Indizes bedenken solltest
Wenn MCV, MCH oder MCHC auffällig sind, lohnt es sich die richtigen Fragen zu stellen. Genau diese Fragen machen am Ende oft den Unterschied zwischen einem „komischen Wert“ und einer sinnvollen Einordnung:
- Sind die Werte eher zu niedrig oder zu hoch?
- Passt das Bild eher zu mikrozytär-hypochrom oder eher zu makrozytär?
- Gibt es Müdigkeit, Blässe, Haarausfall, Kurzatmigkeit oder Konzentrationsprobleme?
- Wurden Ferritin, Vitamin B12 und Folsäure überhaupt schon mitbestimmt?
- Ist das eine einmalige Konstellation oder zeigt sich ein chronischer Verlauf?
Was du aus MCV, MCH und MCHC wirklich mitnehmen kannst
MCV, MCH und MCHC sind keine irrelevanten Nebenwerte. Sie gehören zu den nützlichsten Hinweisen im Blutbild, wenn man verstehen möchte, in welche Richtung eine Blutarmut oder ein Mangelbild denken lässt. Gleichzeitig sollte man sie nie überbewerten. Sie zeigen eine Richtung, aber sie ersetzen keine vollständige Diagnostik. Wenn du merkst, dass dich genau diese Abkürzungen eher verwirren als weiterbringen, dann bist du genau die Person, für die ich Blutgeflüster geschrieben habe. Das Buch hilft dir, Blutwerte in Alltagssprache zu verstehen und Muster zu erkennen, statt nur auf Markierungen, Pfeile und Referenzbereiche zu starren.
Medizinischer Hinweis
Ein einzelner Laborwert erklärt selten das ganze Bild. Die Inhalte auf dieser Seite helfen dir, Zusammenhänge besser zu verstehen. Sie ersetzen keine individuelle ärztliche Beratung, Diagnostik oder Behandlung. Triff medizinische Entscheidungen immer gemeinsam mit einer qualifizierten medizinischen Fachperson.
FAQ: MCV, MCH und MCHC
Wenn du bei MCV, MCH und MCHC über Begriffe wie mikrozytär, hypochrom oder makrozytär stolperst, bist du nicht allein. Genau hier findest du kurze, verständliche Antworten auf die Fragen, die Menschen mit auffälligem Blutbild besonders häufig haben.
Nicht, aber Eisenmangel ist eine häufige Ursache für ein niedriges MCV. Ein solches mikrozytäres Muster kann aber auch andere Gründe haben. Deshalb sollte man immer auch Ferritin (und weitere Eisenparameter) und den gesamten Zusammenhang anschauen.
Ja, das ist möglich. Ein normozytäres Blutbild schließt Eisenmangel nicht sicher aus. Gerade frühe Eisenmangelzustände können im Blutbild noch unauffällig wirken. Wenn deine Beschwerden dazu passen, lohnt sich ein erweiterter Blick auf deine Eisenwerte im Blut. Mehr dazu findest du hier: Ferritin, Eisen & Eisenmangel verstehen.
Diese Konstellation passt häufig zu einem mikrozytär-hypochromen Bild, wie man es klassisch bei Eisenmangel sieht.
Dann kann trotzdem eine Blutarmut vorliegen. Ein normozytär-normochromes Muster bedeutet nur, dass Größe und Hämoglobin-Füllung der roten Blutkörperchen zunächst unauffällig wirken. Die Ursache kann trotzdem ernst zu nehmen sein und gehört immer in den Gesamtkontext.
Weil sie oft stiefmütterlich innerhalb des Blutbilds behandelt werden, obwohl sie sehr hilfreich sein können. Denn sie geben oft die erste Richtung vor, in welchen Ursachen man weiterdenken kann, wenn sie auffällig sind und / oder konkrete Symptome vorliegen.
Ein erhöhtes MCV bedeutet, dass die roten Blutkörperchen im Durchschnitt größer sind als üblich. Klassisch denkt man dann an Vitamin-B12-Mangel oder Folsäuremangel. Aber auch hier gilt: Das MCV allein stellt keine Diagnose. Entscheidend ist das Muster zusammen mit Hämoglobin, Erythrozytenzahl, Vitamin B12, Folat und den Beschwerden.
Ja. Diese drei Werte gehören zu den Erythrozyten-Indizes und werden in der Regel automatisch mitbestimmt, wenn ein Blutbild gemacht wird. Gerade deshalb stehen sie oft auf dem Laborzettel, ohne dass sie jemand im Gespräch wirklich erklärt.
Sinnvoll sind vor allem Hämoglobin, Hämatokrit, Erythrozytenzahl, Ferritin bzw. der Eisenstatus, Vitamin B12, Folsäure und deine individuellen Symptome. Denn die Erythrozyten-Indizes zeigen eine Richtung, aber sie ersetzen keine vollständige Einordnung.
Verwandte Themen
Blutwerte machen selten als Einzelwert Sinn. Wenn du MCV, MCH und MCHC besser einordnen willst, lohnt sich fast immer auch der Blick auf angrenzende Muster wie Eisenstatus, Schilddrüse und Blutzucker. Genau dort entstehen im Alltag oft die Fragen, die auf dem Laborzettel zunächst unsichtbar bleiben.
- Schilddrüsenwerte besser einordnen
- Blutzucker, HbA1c und Insulin besser verstehen
- Ferritin, Eisen & Eisenmangel verstehen
- Blutwerte besser verstehen
Quellen und weiterführende Literatur
Wenn du tiefer in das Thema einsteigen möchtest, findest du hier einige der wichtigsten fachlichen Grundlagen zu Erythrozyten-Indizes, Blutarmut, Eisenmangel und Vitamin-B12-Mangel. Die Auswahl ist bewusst klein gehalten und konzentriert sich auf die Quellen, die für das Verständnis von MCV, MCH und MCHC wirklich tragen.
- Corrons JLV, Casafont LB, Frasnedo EF. Concise review: how do red blood cells born, live, and die? Ann Hematol. 2021;100(10):2425–2433.
- Cappellini MD, Motta I. Anemia in Clinical Practice – Definition and Classification: Does Hemoglobin Change With Aging? Semin Hematol. 2015;52(4):261–269.
- Kaferle J, Strzoda CE. Evaluation of macrocytosis. Am Fam Physician. 2009;79(3):203–208.
- Hannibal L, Lysne V, Bjørke-Monsen AL, Behringer S, Grünert SC, Spiekerkoetter U, Jacobsen DW, Blom HJ. Biomarkers and Algorithms for the Diagnosis of Vitamin B12 Deficiency. Front Mol Biosci. 2016;3:27.
- Nexo E, Hoffmann-Lücke E. Holotranscobalamin, a marker of vitamin B-12 status: analytical aspects and clinical utility. Am J Clin Nutr. 2011;94(1):359S–365S.
